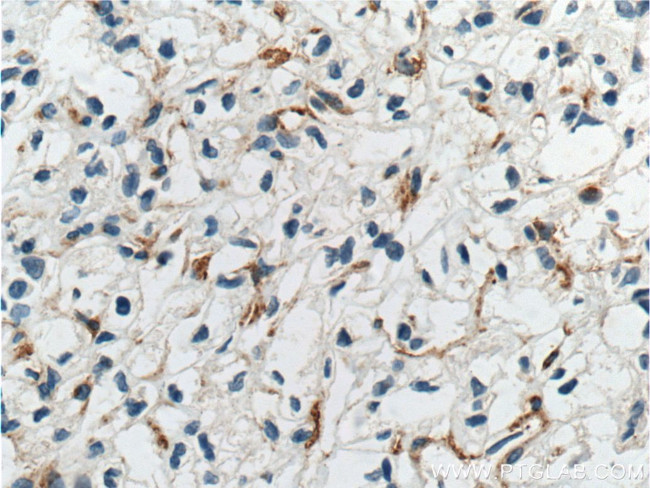
TEM1 Antibody in Immunohistochemistry (Paraffin) (IHC (P))

Search
Proteintech
TEM1 Monoclonal Antibody (1F9B4)
{{$productOrderCtrl.translations['antibody.pdp.commerceCard.promotion.promotions']}}
{{$productOrderCtrl.translations['antibody.pdp.commerceCard.promotion.viewpromo']}}
{{$productOrderCtrl.translations['antibody.pdp.commerceCard.promotion.promocode']}}: {{promo.promoCode}} {{promo.promoTitle}} {{promo.promoDescription}}. {{$productOrderCtrl.translations['antibody.pdp.commerceCard.promotion.learnmore']}}
产品信息
60170-1-IG
种属反应
已发表种属
宿主/亚型
分类
类型
克隆号
抗原
偶联物
形式
浓度
纯化类型
保存液
内含物
保存条件
运输条件
产品详细信息
Immunogen sequence: EPTQPPDFA LAYRPSFPED REPQIPYPEP TWPPPLSAPR VPYHSSVLSV TRPVVVSATH PTLPSAHQPP VIPATHPALS RDHQIPVIAA NYPDLPSAYQ PGILSVSHSA QPPAHQPPMI STKYPELFPA HQSPMFPDTR VAGTQTTTHL PGIPPNHAPL VTTLGAQLPP QAPDALVLRT QATQLPIIPT AQPSLTTTSR SPVSPAHQIS VPAATQPAAL PTLLPSQSPT NQTSPISPTH PHSKAPQIPR EDGPSPKLAL WLPSPAPTAA PTALGEAGLA EHSQRDDRWL (399-687 aa encoded by BC051340)
靶标信息
CD248 (CD248 Molecule) is a Protein Coding gene. Gene Ontology (GO) annotations related to this gene include calcium ion binding and extracellular matrix binding. An important paralog of this gene is CD93. CD248 may play a role in tumor angiogenesis.
仅用于科研。不用于诊断过程。未经明确授权不得转售。
生物信息学
蛋白别名: 2610111G01Rik; CD164 sialomucin-like 1; CD248; CD248 antigen, endosialin; CD248 molecule, endosialin; Endosialin; MGC119478; MGC119479; Tumor endothelial marker 1
基因别名: 2610111G01Rik; AI842296; CD164L1; CD248; TEM1
UniProt ID: (Human) Q9HCU0, (Mouse) Q91V98
Entrez Gene ID: (Human) 57124, (Mouse) 70445